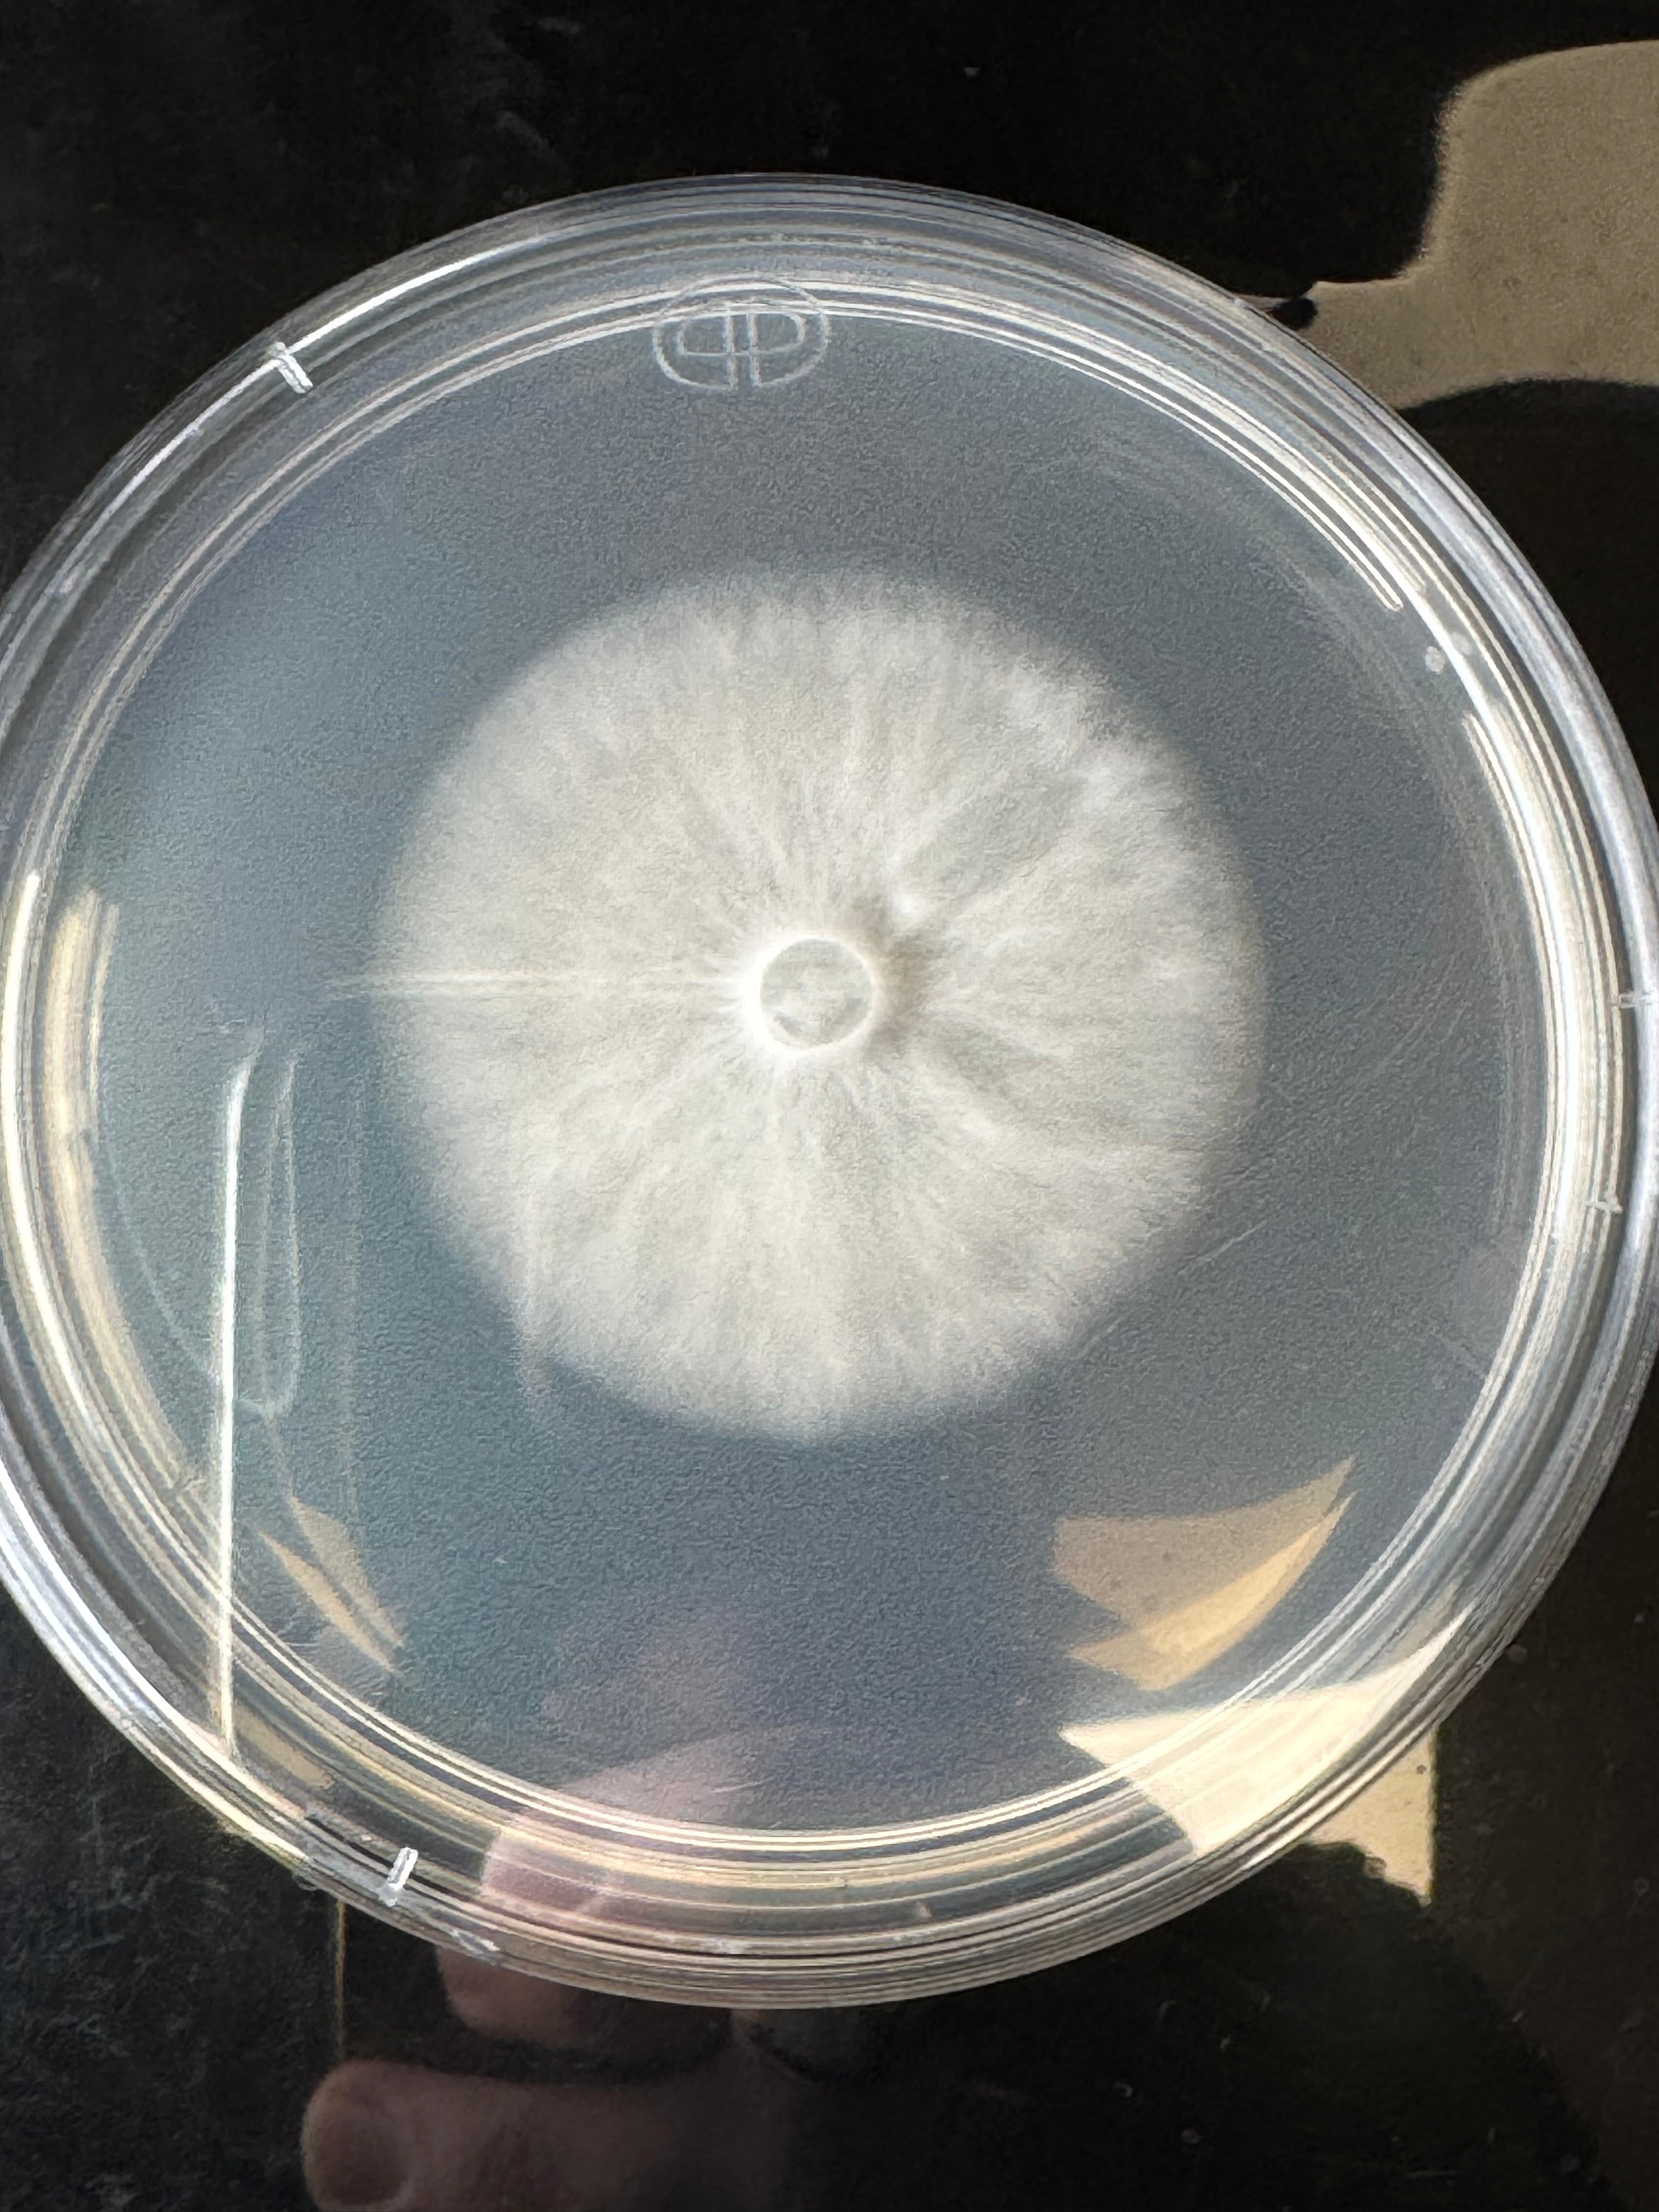
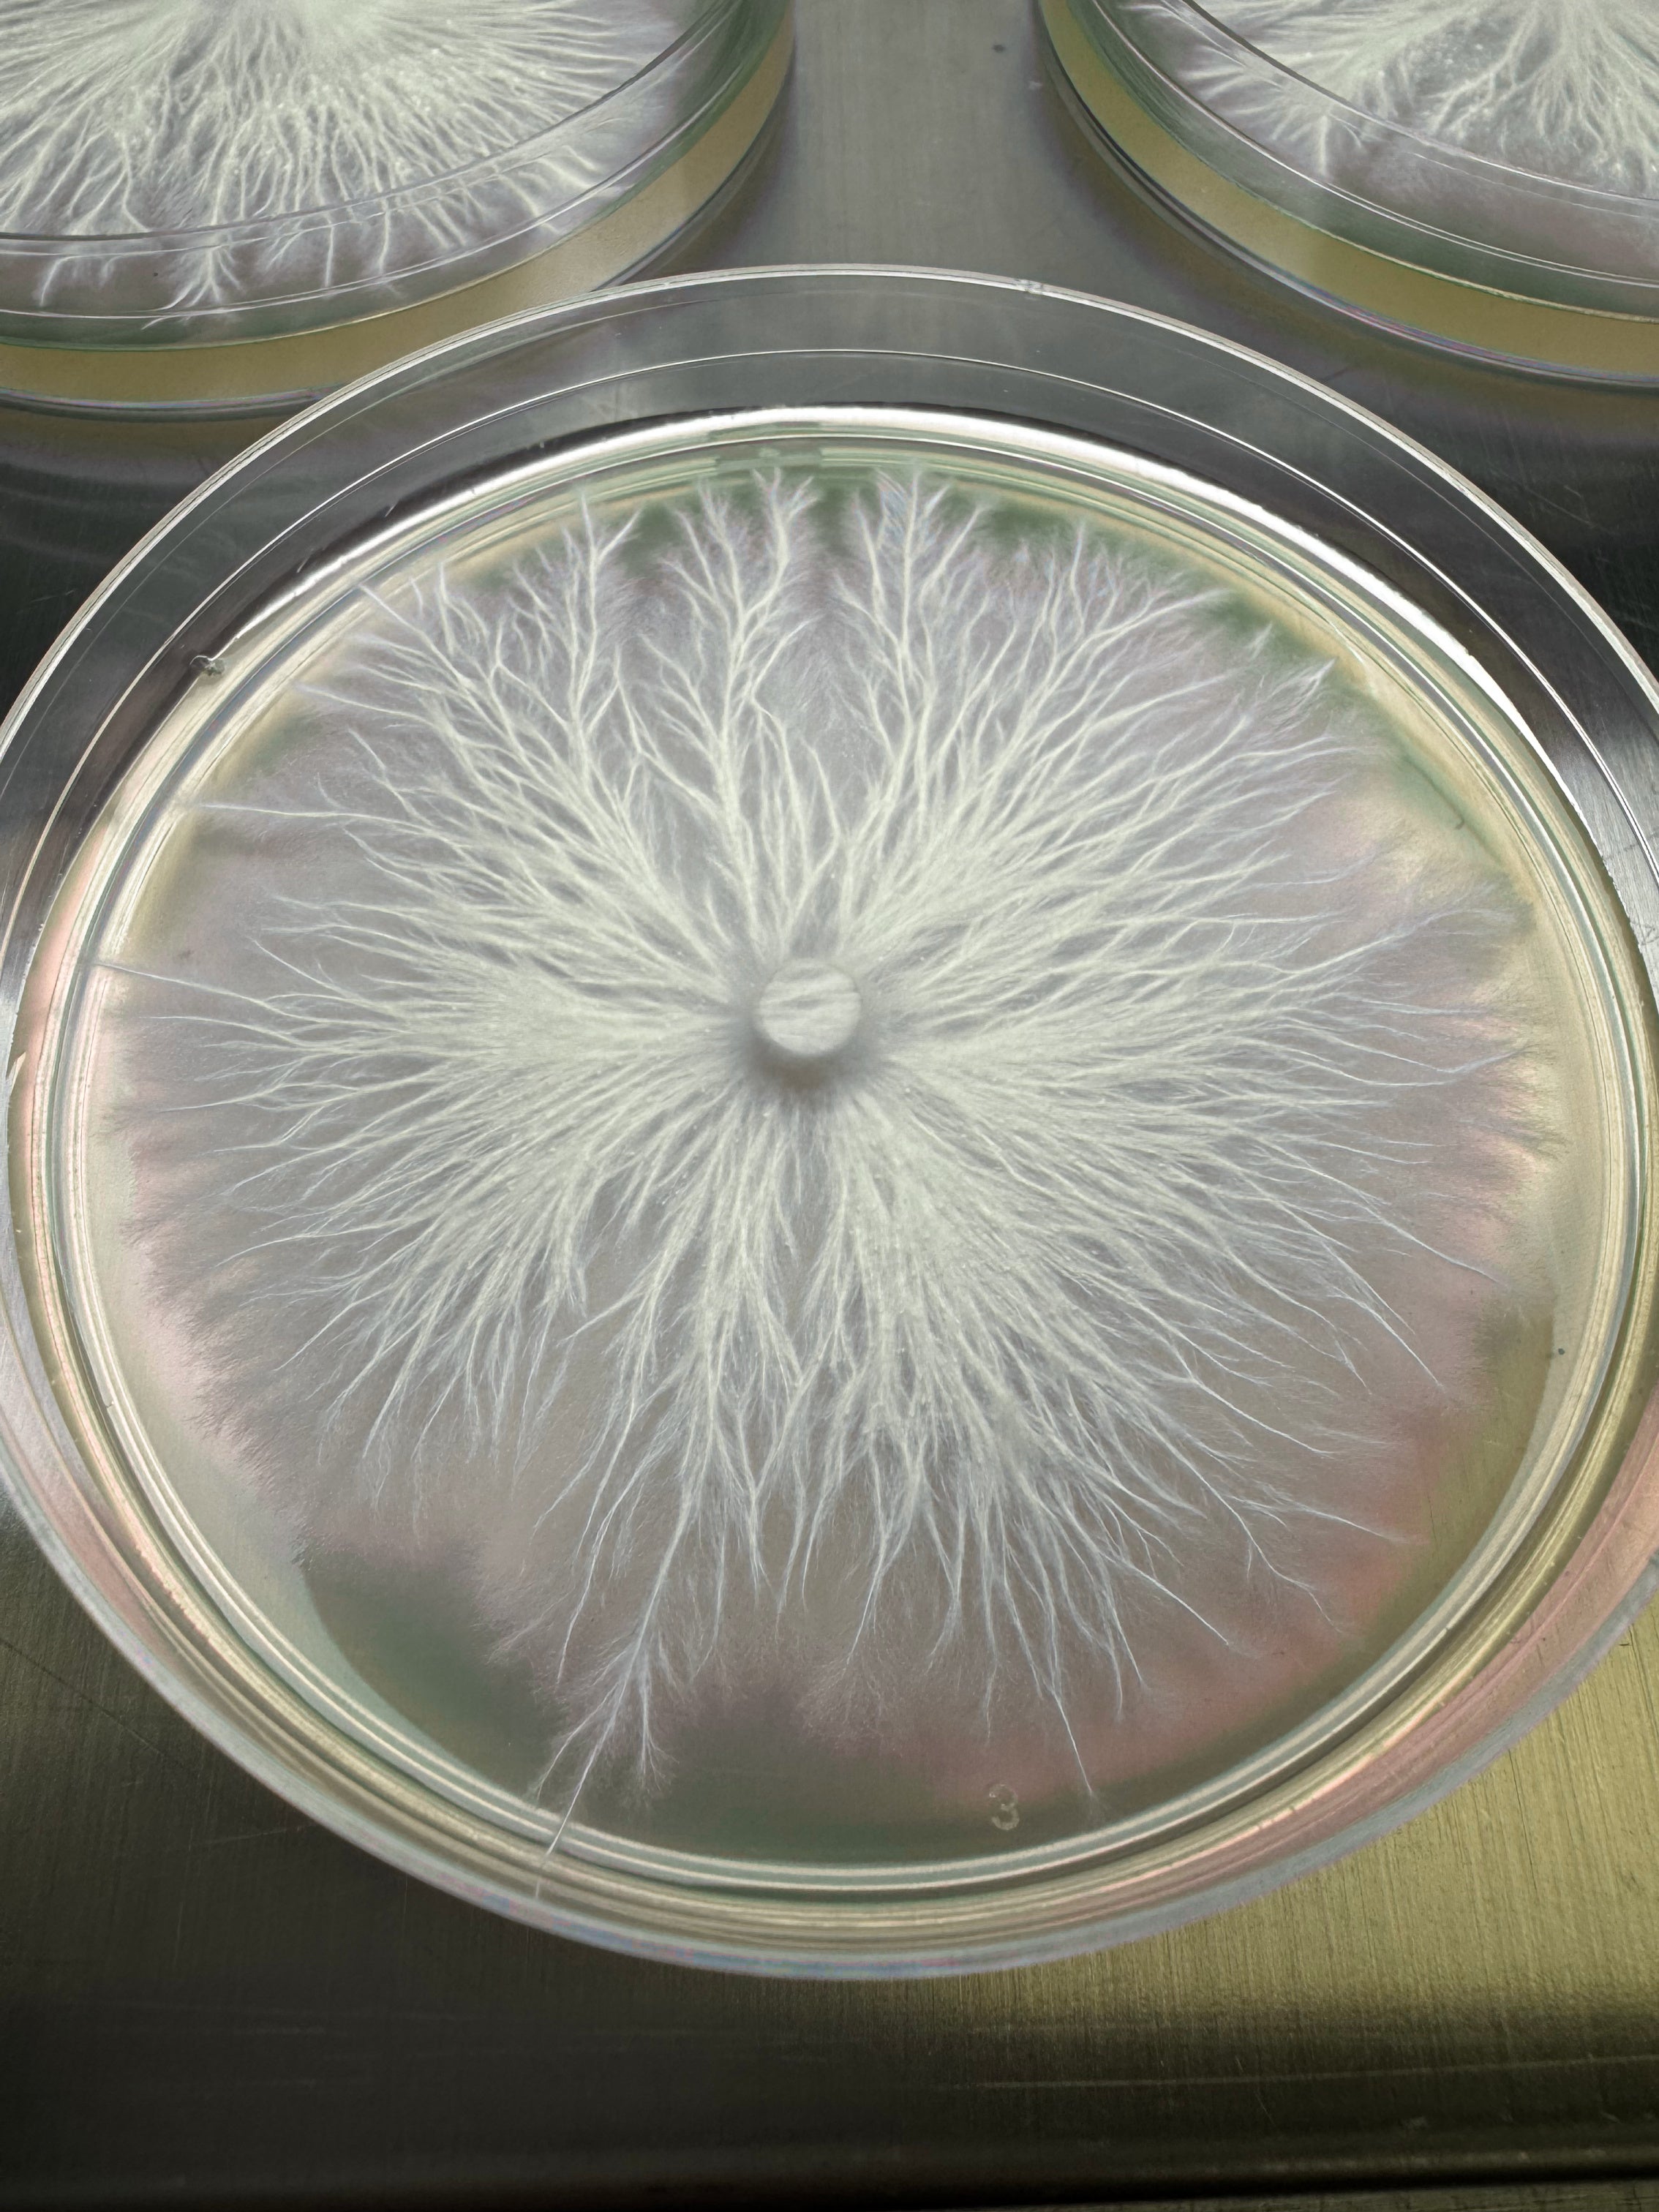

Premium Light Malt Extract (LME) Agar Powder Blend - Makes 200+ Agar Plates 200g (7oz)
Microppose Malt Extract Agar Powder Blend- Custom Blended by Myco Labs USA
Elevate your mycology projects with Microppose Malt Extract Agar Powder Blend—a custom-formulated, pre-mixed solution designed to cultivate vibrant and healthy mycelium. Expertly engineered for consistent performance, this 200g (7oz) blend combines extra light malt extract, our high-strength agar powder, and soy peptone in optimal ratios to promote robust mycelial growth.
Key Features:
- Prepares over 200 nutrient-rich malt extract agar (LME) plates from one bag, making it a cost-effective choice for hobbyists, educators, and professionals.
- Perfect for isolating new strains, cloning mushrooms, or conducting lab experiments.
How to Use:
- Measure the Blend: Use 16g of powder per 500ml of water for standard agar plates. Adjust as needed for specific requirements.
- Dissolve: Mix the measured powder into distilled water, stirring thoroughly.
- Sterilize: Pour the solution into an autoclavable container (e.g., Glass or Pyrex) and sterilize at 15 PSI for 20 minutes in a pressure cooker or autoclave.
- Cool and Pour: Allow the sterilized agar to cool to 120–140°F (50–60°C). Pour into sterile petri dishes in a laminar flow hood or sterile environment.
- Set and Use: Let the agar solidify completely before inoculating with your desired mycelium.
Pro Tip: Store unused powder in a cool, dry place to maintain freshness and optimal performance. Shelf life is 6 months once opened.
Achieve reliable, professional-grade results with Microppose Malt Extract Agar Powder Blend—crafted for success in every pour.
Premium Light Malt Extract (LME) Agar Powder Blend - Makes 200+ Agar Plates 200g (7oz)